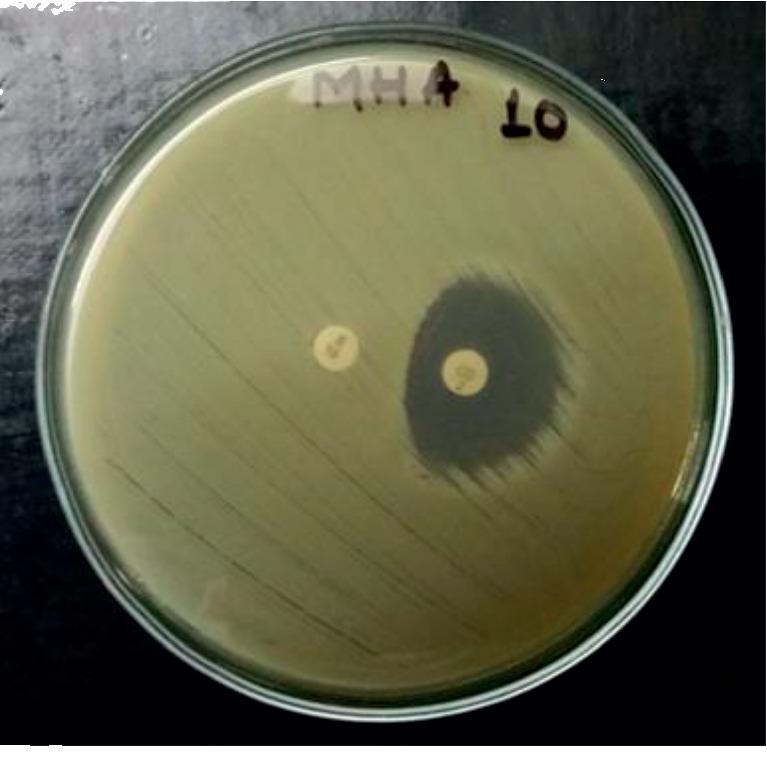
https://cdn.ncbi.nlm.nih.gov/pmc/blobs/7bf7/7068152/7997a2b3de5b/IJMICRO2020-7981648.003.jpg
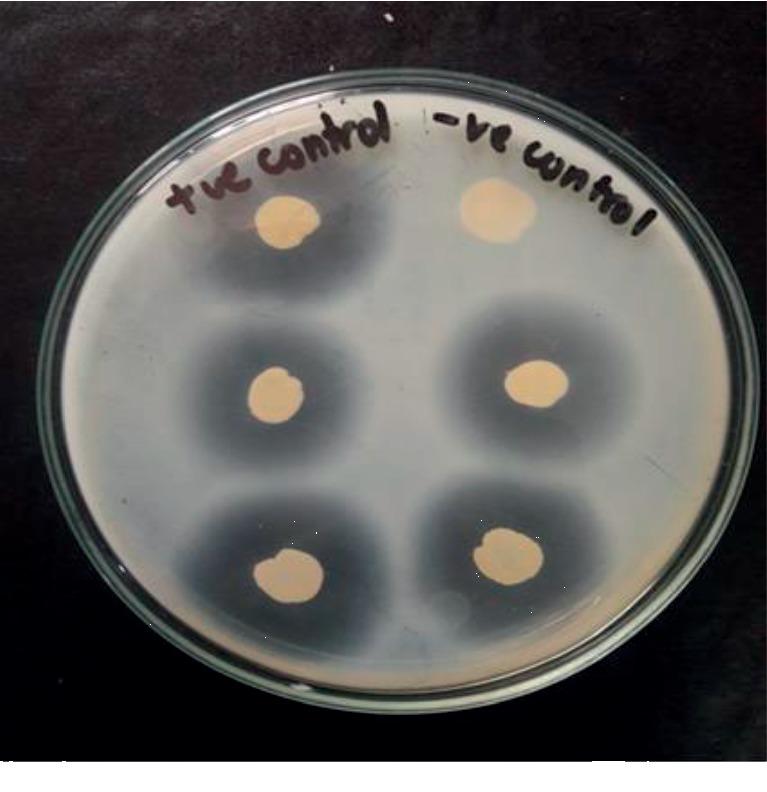
https://cdn.ncbi.nlm.nih.gov/pmc/blobs/7bf7/7068152/06bc243d6f6e/IJMICRO2020-7981648.004.jpg

神社中耐甲氧西林的流行情况。
Prevalence of Methicillin-Resistant in Shrines.
作者信息
Arjyal Charu, Kc Jyoti, Neupane Shreya
机构信息
Tri-Chandra Multiple Campus, Tribhuvan University, Kathmandu, Nepal.
出版信息
Int J Microbiol. 2020 Feb 29;2020:7981648. doi: 10.1155/2020/7981648. eCollection 2020.
Methicillin-resistant (MRSA) infection in human beings and animals is concerning; it stands out as one of the leading agents causing nosocomial and community infections. Also, marginally increasing drug resistance in MRSA has limited therapeutic options. This study focuses on estimating the prevalence of MRSA in shrines, a place where human and animal interaction is frequent, sharing antibiotic-resistant bacteria, antibiotic-resistant genes, and diseases. A total of 120 environmental swabs were collected from targeted areas during the study period, March 2018 to May 2018. was identified by growth on mannitol salt agar (MSA), and MRSA by growth on mannitol salt agar containing 4 g Oxacillin, Gram staining, and conventional biochemical test. Isolates of were characterized by antibiotic susceptibility testing using the disc diffusion method. MRSA and methicillin-sensitive (MSSA) proportion were 19% and 81%, respectively; a high rate of MRSA was observed in isolates from Thapathali (28.6%). MSSA isolates showed a high rate of resistance to erythromycin (64.7%). MRSA isolates were resistant to gentamicin (50%), cotrimoxazole (25%), erythromycin (50%), and ciprofloxacin (25%). The isolates were susceptible to linezolid (100%), clindamycin (100%), ciprofloxacin (75%), erythromycin (50%), tetracycline (100%), and cotrimoxazole (75%). Intermediate resistance was also found in gentamicin (50%). Of the 11 MSSA isolates that were erythromycin resistant and clindamycin sensitive, 6 (54.5%) showed the inducible clindamycin resistance (ICR) pattern and 2 MRSA isolates that were erythromycin resistant and clindamycin sensitive showed ICR pattern. Fifteen MSSA isolates were -lactamase positive, whereas only two MRSA isolates showed -lactamase production. There exists a minimal research work on infectious diseases that are shared between primates and animals. This study suggests the pervasiveness of MRSA/MSSA in the shrines, which may be a primary place for pathogen exchange between humans and primates.
人类和动物中的耐甲氧西林金黄色葡萄球菌(MRSA)感染令人担忧;它是导致医院感染和社区感染的主要病原体之一。此外,MRSA耐药性的逐渐增加限制了治疗选择。本研究的重点是估计圣地中MRSA的流行情况,圣地是人类与动物频繁互动、共享抗生素耐药菌、抗生素耐药基因和疾病的地方。在2018年3月至2018年5月的研究期间,共从目标区域采集了120份环境拭子。通过在甘露醇盐琼脂(MSA)上生长来鉴定金黄色葡萄球菌,通过在含4 g苯唑西林的甘露醇盐琼脂上生长、革兰氏染色和常规生化试验来鉴定MRSA。使用纸片扩散法通过抗生素敏感性试验对金黄色葡萄球菌分离株进行鉴定。MRSA和甲氧西林敏感金黄色葡萄球菌(MSSA)的比例分别为19%和81%;在塔帕塔利的分离株中观察到较高的MRSA发生率(28.6%)。MSSA分离株对红霉素的耐药率较高(64.7%)。MRSA分离株对庆大霉素(50%)、复方新诺明(25%)、红霉素(50%)和环丙沙星(25%)耐药。分离株对利奈唑胺(100%)、克林霉素(100%)、环丙沙星(75%)、红霉素(50%)、四环素(100%)和复方新诺明(75%)敏感。在庆大霉素中也发现了中度耐药(50%)。在11株对红霉素耐药且对克林霉素敏感的MSSA分离株中,6株(54.5%)表现出诱导型克林霉素耐药(ICR)模式,2株对红霉素耐药且对克林霉素敏感的MRSA分离株表现出ICR模式。15株MSSA分离株β-内酰胺酶阳性,而只有2株MRSA分离株产生β-内酰胺酶。关于灵长类动物和动物之间共享的传染病的研究工作极少。本研究表明圣地中MRSA/MSSA普遍存在,这可能是人类与灵长类动物之间病原体交换的主要场所。